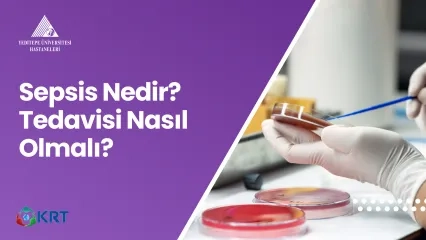
Sepsis Nedir? Tedavisi Nasıl Olmalı?

Alo Yeditepe
Sepsis Nedir?
Sepsis acil bir durumdur. Ne yazık ki, sepsis nedeniyle her 3-4 saniyede bir kişi yaşamını kaybetmektedir. Birçok enfeksiyon hastalığında yaşam kaybı, sepsis nedeniyle gerçekleşir.
Vücudun enfeksiyon ile savaşında rol alan bağışıklık sistemi, vücudun kendi doku ve organlarında hasara neden olunca sepsis ortaya çıkar. Bu durum organ yetmezliklerine ve sonucunda yaşam kaybına neden olabilir.
Sepsis acil bir durumdur. Ne yazık ki, sepsis nedeniyle her 3-4 saniyede bir kişi yaşamını kaybetmektedir. Birçok enfeksiyon hastalığında yaşam kaybı, sepsis nedeniyle gerçekleşir.
Sepsis Neden Oluşur?
Enfeksiyonların birçoğu sepsise yol açabilir. Bunlar arasında zatürre, idrar yolu enfeksiyonları, karın içi enfeksiyonlar, deri veya yara enfeksiyonları ya da menenjit gibi yaygın olarak görülen enfeksiyonlar vardır. Grip, sıtma, dank humması, sarı humma ve ebola gibi enfeksiyon hastalıklarının tümü sepsis ile sonuçlanabilir.
Sepsise neden olan enfeksiyonların %80’inden fazlası hastane dışında kazanılır. Herkes sepsis olabilir. Özellikle bağışıklık sistemi zayıflamış olan kişiler risk altındadır. Bunlar 60 yaş üzerindeki erişkinler, 1 yaş altındaki çocuklar, kronik akciğer, karaciğer, kalp hastalığı olan kişiler, şeker (diyabet) ya da AIDS hastalığı olanlar veya dalağı olmayan kişilerdir.
Sepsisin Belirtileri Nelerdir?
Sepsis bazı belirti ve bulgularla belirlenebilir:
- Sersemlik ve geveleyerek konuşma
- Aşırı titreme
- Kas ağrısı
- AteşŞiddetli nefes darlığı
- Gün boyu idrar yapamama
- Solgun, benekli, rengi değişmiş cilt
- Ölecekmiş gibi hissetme
Sepsis Nasıl Önlenir?
Sepsisi önlemenin en kolay yolu enfeksiyonların önlenmesidir. Bu da aşılama ve temel hijyenle yapılabilir. Bir enfeksiyon sepsise yol açmışsa hızlı bir şekilde tanınmalı ve enfeksiyonun kaynağı antibiyotiklerle tedavi edilmelidir. Enfeksiyonların erken tedavisi ve sepsisin erken tanınması hayat kurtarır.
Sepsis dünyadaki en önlenebilir yaşam kaybı nedenidir. Aşılama, temiz sağlık tesislerine, temiz suya erişim gibi sağlık önlemleri ve hepsinden önce farkındalığın artırılmasıyla önlenebilir. Hayatta kalan pek çok kişi uzun vadeli sonuçlarla karşı karşıya kalır. Parmak veya uzuv kayıpları, hafıza ve konsantrasyon zayıflığı veya travma sonrası stres bozukluğu vb gibi…
Sepsis Farkındalık Günü
Sepsis krizinin önlenmesine yardımcı olabilirsiniz. Sevdiklerinizi bilgilendirin. Her yıl 13 Eylül’de “Dünya Sepsis Günü”ne katılın. Farkındalığın artırılması, sepsisin önlenmesi için destek olun. Ne kadar çok kişi sepsisi bilirse o kadar çok kişi güvende olur.
Bu içerik Yeditepe Üniversitesi Hastaneleri Tıbbi Yayın Kurulu tarafından hazırlanmıştır.
”
İlgili Yazılar
- Hantavirüs İnsandan İnsana Bulaşır mı?
- Hantavirüs Nedir? Belirtileri, Tedavisi ve Korunma Yolları
- Sıcak Havalarda Görülen Enfeksiyonlar
- Hepatit B Nedir? Belirtileri Nelerdir? Nasıl Bulaşır?
- Grip Belirtileri Nelerdir? Gribe Ne İyi Gelir? Grip Nasıl Geçer?
- HMPV Virüsü Nedir? HMPV Belirtileri ve Bulaşma Yolları
- Grip Bu Yıl Neden Uzun Sürüyor?
- Hemoglobin(HGB) Nedir? HGB Düşüklüğü ve Yüksekliği
- Antibiyotikler Neden Artık İşe Yaramıyor?
- Epidural Anestezi Nedir? Nasıl Uygulanır?
- Batı Nil Virüsü Nedir? Belirtileri Nelerdir, Nasıl Bulaşır?
- Viral Hepatitler ve Korunma Yöntemleri
- Soğuk Algınlığı Salgınına Karşı Hangi Önlemler Alınmalı?
- Sepsis Hakkında Bilinmesi Gerekenler
- Hepatit Nedir? Belirti ve Tedavi Yöntemleri Nelerdir?
- Kene Isırması Belirtileri ve Tedavisi
- Talasemide Enfeksiyona Bağlı Yaşam Kayıplarına Karşı Önlem Alınmalı
- Ofiste Hijyen: Mikropların Ofiste En Çok Bulunduğu Noktalar
- Corona Virüsü Nedir?
- Strep A Belirtileri ve Tedavisi
- Sepsisi Önlemenin Yolları
- H1N1 (Domuz Gribi) Hakkında Bilgilendirme
- Yaz Geliyor... Gıda zehirlenmelerine dikkat!
- Yaz Enfeksiyonlarının Korunmak İçin Öncelikli Kural Hijyen!
- Maymun Çiçeği Virüsü Kimleri Tehdit Ediyor?
- DSÖ Antibiyotik Direnci İçin Alarm Zillerini Çalıyor!
- Toplumsal Tabularımız Türkiye’de HIV Pozitif Vaka Sayısındaki Artışı da Etkiliyor
- Okula Giden Çocukları Covid-19’dan Koruma Yolları
- Maymun Çiçeği Virüsü
- Lyme Hastalığı Nedir?
- Sepsis Belirtileri ve Tedavisi
- Maske Zorunluluğu Kalktı Sosyal Mesafenin Önemi Arttı!
- Domuz Gribi / H1N1
- Kenenin Üzerine İzmarit Basmayın, Zeytinyağı, Sıvı Sabun Dökmeyin
- Seyahate Çıkmadan Önce Mutlaka Okuyun!
- Hastalıklarla Mücadele İçin Geç Kalmayın
- Zika Virüsü En Çok Anne Adaylarını Tehdit Ediyor
- Soğuk Algınlığında ve Gripte Hemen Antibiyotiklere Sarılmayın
- Yetişkinlerde Hangi Aşı, Ne Zaman Yapılmalı?
- Karaciğer Kanseri ve Karaciğer Naklinin Yüzde 60 - 70’ i Kronik Hepatit Kaynaklı
- Geçmeyen Grip İçin Ne Yapmalı?
- Corona Virüsten Korunma Yolları
- Coronavirüsü Nedir?
- Pişirdiğiniz Yemeği Sadece Bir Kere Isıtın
- Hayat Tedbirle Normale Dönüyor
- Çocukları COVID-19’dan Koruma
- Koronavirüsü Hafif Geçirdiğimiz Nasıl Anlaşılır?
- COVID-19 için Bu Kurallara Dikkat
- Mutfak Alışverişinde Hijyen Dönemi
- El Dezenfektanı Kullanma Rehberi
- Kişinin Ateşi Yoksa ‘Hasta Değil’ Anlamına Gelmeyebilir
- Koronavirüs COVID-19 Belirtileri
- Koronavirüs Sık Sorulan Sorular
- Grip mi? Koronavirüs mü?
- Anestezi Öncesi Bitkisel İlaçların Güvenli Kullanımı
- Omicron Varyantı
- Antibiyotik Direnci Konusunda Dünya “Alarm” Veriyor!
- Sepsis Her 2,8 Saniyede 1 Kişinin Yaşamına Mal Oluyor!
- Sivrisinekte Enfeksiyon Riski
- Korunabilmek için Sağlıklı Olmaya Çalışmak Gerekiyor
- Reçete Maliyetlerinin Yüzde 14’ünü Antibiyotikler Oluşturuyor
- Sepsiste İlk 1 Saat Hayat Kurtarıyor
- Talasemi ile Mücadele Eden Meralin Örnek Başarısı
- Antibiyotikler Virüsleri Değil Faydalı Bakterileri Öldürüyor
- Türkiye' de Her Yıl Yaklaşık 3 Milyon Hasta Kan Transfüzyonuna İhtiyaç Duyuyor
- Vektörle Bulaşan Hastalıkların Yüzde 63’ünün Nedeni, Lyme Hastalığı
- Uzmanlar Grip Tehlikesine Karşı Uyardı
- 10 Yılda Bir Yeni Grip Salgını Bekleniyor
- Batı Nil Virüsü Sıtmanın Yerini Aldı
- Anesteziye Bağlı Yaşam Kaybı 100.000’ de 1’ e Geriledi
- Grip Aşısı Ne Zaman Yaptırılmalı?
- Grip Aşısı Yaptırmak İçin Hala Geç Değil
- Bayramda Ete Dokunurken Dikkat Edilmesi Gerekenler
- HIV Belirti Vermeden 10 Yıl Gizlenebiliyor!
- Kırım Kongo Kanamalı Ateşinde Erken Tedavi Hayati Önem Taşıyor
- Rhinovirüsü Nedir?
- Şarbon Nasıl Bir Hastalıktır?
- Talasemi Göçlerle Akdeniz’den Tüm Avrupa’ya Yayılıyor!
- 290 Milyon Kişi Hepatitli Olduğunu Bilmeden Yaşıyor
- AIDS ile Mücadelenin Yolu Farkındalığı Artırmaktan Geçiyor
- Yaz Enfeksiyonları
Alo Yeditepe
İlgili Doktorlarımız
İlgili Tıbbi Birimlerimiz
İlgili Videolar
Video içeriği